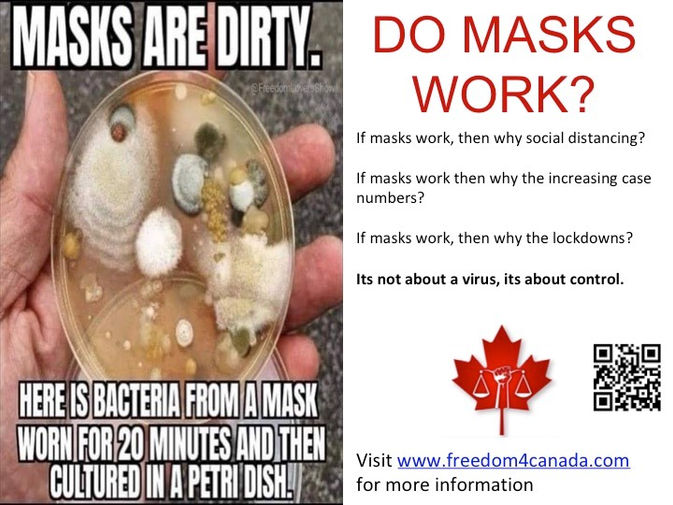

Breaking News:
UPDATED WEEKLY:
Download this PDF summary and share it EVERYWHERE!
(updated regularly - check back weekly for latest version!)
Enjoy reading this FREE flipbook version of The Covid Report. For a downloadable and printable PDF version with clickable links, click the icon to access our digital store.
OR
Save us the 10% commission and click the DONATE button, then choose The Covid Report membership option.
Before you look further...
Have you ever wondered who the Facebook FactCheckers are and who checks their facts? Ben Swan with ISE Media investigates the facts. Understand that they will try to deter you from learning the truths revealed on this site so be forewarned about censorship and the rewriting of history.
Are you this easily manipulated?
Here is a great example of how people can be programmed to follow the crowd within minutes without regard to any evidence in support of their ridiculous actions. This is called psychological programming and is being used on you right now with social distancing, masking, sanitizing, and vaccinations. Don't be like a lamb to slaughter; learn to think for yourself. This site will help!
URGENT!
This might be the most important post on this site!
One of the Top Pro-Vaccine developers in the world just issued an incredible warning to world-wide leaders to IMMEDIATELY STOP the mass vaccination of the world before we have a MASS CASUALTY EVENT caused by immune escape!
Ask the Experts
The Questions on Everyone's Minds
An Oracle Films Production
The official media team of World Freedom Alliance of Doctors
Don't take our word for it. Before you look at anything else on this site, or even read the PDF summary article above, listen to what 33 other leading medical experts from around the world have to say about Covid19, the Experimental Gene Therapy so-called "Vaccine", forced vaccinations, medical genocide, auto-immune system priming, the Nuremberg Code, and the REAL hidden agenda behind the current events.
See below for a list of the doctors, scientists, and other professionals featured in this film.




The Covid Report: https://lbry.tv/@TheCovidReport:0
The link above contains a fantastic collection of videos related to the worldwide Covid-19 fraud. Mostly being perpetrated via fake positives generated with fake RT-PCR positives. Each video in this collection provides insight into the global conspiracy being committed by the criminal oligarchy.
November 19th, 2020
Former Pfizer Vice President Dr. Mike Yeadon discusses his thoughts as to why the lockdown was a mistake, and why the government strategies to manage the pandemic are only making things worse. The Scientific Advisory Group for Emergencies (SAGE) is a British Government advisory body that advises central government in emergencies.
Dr. Mike Yeadon is an Allergy & Respiratory Therapeutic Area expert, developed out of deep knowledge of biology & therapeutics and is an innovative drug discoverer with 23 years in the pharmaceutical industry. He trained as a biochemist and pharmacologist, obtaining his PhD from the University of Surrey (UK) in 1988 on the CNS and peripheral pharmacology of opioids on respiration. Dr Yeadon then worked at the Welcome Research Labs with Salvador Moncada with a research focus on airway hyper-responsiveness and effects of pollutants including ozone and working in drug discovery of 5-LO, COX, PAF, NO and lung inflammation. With colleagues, he was the first to detect exhaled NO in animals and later to induce NOS in lung via allergic triggers.
Joining Pfizer in 1995, he was responsible for the growth and portfolio delivery of the Allergy & Respiratory pipeline within the company. During his tenure at Pfizer, Dr Yeadon was responsible for target selection and the progress into humans of new molecules, leading teams of up to 200 staff across all disciplines and won an Achievement Award for productivity in 2008. Under his leadership the research unit invented oral and inhaled NCEs which delivered multiple positive clinical proofs of concept in asthma, allergic rhinitis and COPD. He led productive collaborations such as with Rigel Pharmaceuticals (SYK inhibitors) and was involved in the licensing of Spiriva® and acquisition of the Meridica (inhaler device) company.
Dr. Yeadon has published over 40 original research articles and now consults and partners with a number of biotechnology companies. Before working with Apellis, Dr. Yeadon was VP and Chief Scientific Officer (Allergy & Respiratory Research) with Pfizer. He left Pfizer in 2011 as Vice President & Chief Scientist for Allergy & Respiratory and eventually founded his own biotech company, Ziarco. In 2017 Dr. Yeadon sold Ziarco to Novartis, one of the world's largest pharmaceutical companies.
Video deleted from YouTube? Click the uncensored rumble version below.
BRAND NEW Covid Statistical Analysis
Ivor Cummins explains how to honestly interpret the real data.
Learn why Lockdowns don't work but destroy economies!
Statistics
Statistics


What Are Your Odds of Dying From ... (2018 Data)

PCR Vs Rapid Antigen - Safely Opening Up Society - a Rational, Technical Approach

CTV News Edits Clip on Canada's Death Count 166 real

"There's No Justification for Another Lockdown" - Ivor Cummins
"It is much easier to fool a man than it is to convince him he has been fooled" ~ Mark Twain
If you only read ONE POST on this site, READ THIS ONE!
Hindsight is 20/20
As editors, researchers, and reporters of this independent news station, we see the new decade as a humongous wake-up opportunity to use the benefit of 20/20 hindsight to learn from history and reveal to our viewers the hidden truths about the real-life matrix we find ourselves living in. Secret societies, 322 Skull & Bones, hidden agendas, "conspiracy theories", media propaganda, money and stock market manipulation, false flag terrorism, the Georgia Guidestones, the Deep State, the military industrial complex, 5G wireless RF radiation, and numerous other topics such as the New World Order will be discussed here to help you see the BIG PICTURE...
If you are not willing to do a lot of research to get to the truth; if you are just looking for a quick sound bite answer to your many questions; if you blindly believe everything you hear on the main stream (lame stream) media TV or read in the newspaper without fact-checking it for yourself; or if you are generally lazy, then this site may not be for you.
On the other hand, if you are ready to truly be informed with extremely well-researched and documented information from some of the leading experts in the fields (many whom would be considered expert witnesses in a court of law) but which is apparently too dangerous to the perpetrators of so many of these crimes, then keep reading.
This site has been designed to be read in sequence with this Home page and Home Page 2 being the only two sections you really need to review to get the BIG PICTURE of what is gong on with Covid19. The rest of the site provides verification, back-up research, and resources that validate the content here.
To get the big picture, start with the section below for an expanded introduction to our site. If you have already been there, then jump to the recommended steps section.
If you simply read every article on these first two pages and watch every embedded video, you should have more than enough information to understand what is really going on. The rest of the site contains valuable supporting research and hundreds of connected videos that will provide further confirmation that will enhance your knowledge immensely.
Oh, and don't forget to share!
What the Mainstream Media is NOT telling you about the Coronavirus
2020 - A year that will be forever known as the year of the Covid19 mass pandemic, millions dead, world oil and stock market collapses, mass financial bailouts, economies destroyed, quantitative easing QE Infinity, medical martial law, civil unrest, military occupation in cities worldwide, toilet paper and food shortages, disrupted supply chains, 75% empty hospitals, mass unemployment, destroyed small businesses, nationalization of entire economic sectors, panic-stricken citizens scurrying like mice to their hovels to hide from an unseen (and yet unproven to exist!) microscopic enemy, physical distancing enforced by police state decree, forced vaccinations, travel bans, closed borders, and essentially your worst nightmare scenario Hollywood disaster movie coming to life as was foreshadowed in numerous science fiction movies such as Outbreak, Andromeda Strain, 28 Days, Contagion, and so on. But is this all real? Is it blown out of proportion? Or is there something more sinister going on under the surface? What is the real agenda? To answer these and other questions, we need some important background. It will take time but all the research material you need to get started is on this site, so let's begin.
WATCH THIS SUPERB VIDEO SUMMARY FIRST:
HOW "THEY" PULLED OFF THE ‘PANDEMIC’ – AN ANIMATED FILM EXPLANATION BY DAVID ICKE
For a graphic of this global cult, see the Trillionaire Shadow Government picture at the bottom of this page.
Bill Gates sums up the PLANdemic depopulation agenda in his own words. Priceless but true!
Featured Videos of the Week
How PCR Testing is Fraudulent
As cases of coronavirus rise across America, shouldn’t death rates be going up too? Del breaks down how #COVID tests may be seriously flawed by providing less than accurate results and why the majority of positive cases could be false. Watch on YouTube at https://youtu.be/a6HRvBhT6rw.
Please watch & share this video everywhere!
Depopulation Plans Revealed
In this interview with Claire Edwards, a former FEMA operative, we learn about magnetic beacons on the tips of the PCR tests to track and control test recipients, depopulation agendas that have been well-planned for decades, and vaccines that will sterilize, maim, and kill billions.
Please watch & share this video everywhere!
The Dangers of Masks
Government trained OSHA mask experts Tammy Clark & Kristen Meghan join Del in-studio to break down vital info on masks, PPE, and their role in Covid19 prevention. They discuss Occupational Safety & Health regulations, hypoxia, hypercapnia, and CO2-induced immunity suppression. Every adult on this planet wearing a mask needs to hear this riveting discussion. Source: https://thehighwire.com/videos/mask-whistleblowers-tell-all/
Please watch & share this video everywhere!
10,000+ ppm CO2!
'The HighWire's host Del Bigtree and son, Ever, conducted a test, using an OSHA-approved Carbon-Dioxide meter, which revealed something about masks which YouTube, Facebook, and other video platforms are trying very hard to censor. Is this too much CO2 for a kid to rebreathe for entire day at school; what do you think?
Please watch & share this video everywhere!
Most People Don't Realize What's Happening 2020!
David Icke - IT'S WORSE THAN WE THOUGHT (It's Happening Again still nobody knows it)
Original Source: www.kla.tv/17619
The former Apostolic Nuncio in the USA, Vatican diplomat and titular archbishop Carlo Maria Viganò, is repeatedly in the news. On August 26, 2018, he revealed that Pope Francis had been aware of the sexual abuse cases of minors by ex-Cardinal Theodore McCarrick since June 2013 and not only since July 2018, when the New York Times reported on it. Since then Viganò has been suspended from his offices and duties and lives underground. For security reasons he keeps his whereabouts secret. After several critical comments on the Corona measures in 2020, he wrote an open letter to the US president in early November 2020 about the purpose of the Covid19 hoax, that being the Great Reset. Here are some extracts from the letter:
(see also this post)
RECOMMENDED STEPS
-
Read our Introduction to CV19 News article below which is updated frequently.
-
Read the six posts that follow the introduction.
-
Watch the feature video on The Media's Lies.
-
Review the critical information section on Masks,
-
Read the lengthy article on Exosomes. It is a standalone shareable post.
-
Watch the quick movie above "How They Pulled Off The Pandemic"
-
Click the blue button in the footer to Proceed to Page 2 for the more "must see" articles.
All of our collective Liberty is literally at stake right now, in this time, and a Nazi-style global tyranny with high-technology surveillance & control is just a step away if we don't learn from history and stop it now!
For a full video portfolio, click Videos here or in the menu above.
Breaking News: Understanding the RT-PCR Test
Our Latest Posts

Re-designated Flu stats?
<---
4.1% < 60
87.7% >70
Why is anyone under age 65 (83.2% of the population) not fully back to work at 100% capacity?
Seasonal pattern of the flu. Lower deaths than April even after lockdowns and masks! Yet cases have surged. Mitigation has NO effect!


1840-90 Telegraph Wires
1889-95 AC Harnessed => 1889 Flu Epidemic
1918 Massive Radiowave Tech => Flu
(SF began Sept 1918 - same month as a 50,000 Watt Alternator in New Jersey)
(click to view and share)
Covid19 Education Webinar Level 1 - Weekly Live Training Event with AJ from CV19News.
What Do Real Experts Say About Masks?
If a mask (that doesn't protect against ANY virus as labeled on the box) causes a bacterial infection on your face, what do you think it is doing to your lungs? Pneumonia leading to a life-altering positive Covid19 test perhaps? Click to learn more.

DOCTOR DEMONSTRATES WHY FACE MASKS DO NOT & WILL NOT STOP COMMUNITY SPREAD OF COVID
Original Source: https://www.bitchute.com/video/JfUhTjoOF5vz/
For all you "Pro Mask" proponents and those who claim it is "simple logic", well...... here is one from Dr Ted Noel, an anesthesiologist with 36 years of experience who recently uploaded this little inconvenient video contrasting the MSM and self proclaimed elites' narrative that face masks protect or even mitigate community spread. So who exactly will be protected?
Do You Think Masks are Safe & Effective?
Click to read the article.
Masks are DANGEROUS to your health when worn daily by citizens!
(click to read the full post)
CLAY CLARK GATHERS TULSA OKLAHOMA DOCTORS SUE CITY OVER MASK MANDATES
Dr. Lee Merritt speaking on Masks, Lockdowns!
(click to read the full post)
Exosomes, Virus, and the RT-PCR Tests
(Intro 3)
Should you take the Covid19 Test?
Have you heard of the emerging theory that viruses might really be Exosomes? Are you absolutely certain that COVID-19 is contagious? How confident are you in the results from the test?
Deleted from YouTube? Watch it on Bitchute.
Flaws in Coronavirus
Pandemic Theory
What does the Covid19 RT-PCR test Actually test for?
198 people were sickened at this wet fish market. Lung fluid samples from 7 people with bacterial pneumonia were tested without first isolating, purifying, or identifying any suspect organism and then grown in impure culture dishes.
Pandemic or Food Poisoning? You Decide!
![]() | ![]() | ![]() |
|---|---|---|
![]() | ![]() | ![]() |
Dr. Kaufman explains to 1000's in Trafalgar Square London, UK that NO VIRUS has been isolated or proven to even exist!
Deleted from YouTube? Watch it on Bitchute here.
Crimes against Humanity.
Dr. Reiner Fuellmich discusses the fraudulent use of the RT-PCR test and the legal class action compensation that will be paid to those terrorized by governments, media, and medical establishments.
Deleted from YouTube? Watch it on Bitchute here.
Great Barrington Declaration
This public declaration by leading health experts was published on October 4, 2020 and is now signed by over 45,000 verified public health practitioners from around the world, and over 600,000 concerned citizens and counting.
As infectious disease epidemiologists and public health scientists, we have grave concerns about the damaging physical and mental health impacts of the prevailing COVID-19 policies, and recommend an approach we call Focused Protection. Click here to read the full declaration.
BUT WHO ARE "T H E Y"?
THE HIERARCHY ENSLAVING YOU.
HERE THEY ARE: